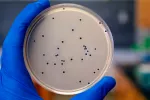
Causas del impétigo

Qué es el impétigo

Por: David Saceda Corralo
Médico Interno Residente, especialista en Dermatología Medicoquirúrgica y Veneorología
Actualizado: 5 de septiembre de 2022
Se llama impétigo vulgar o impétigo contagioso a una infección de la piel producida por bacterias, que afecta principalmente a niños pequeños. La piel está formada por varias capas de células y la más superficial está cubierta por una capa impermeable hecha de una sustancia llamada queratina. Esta sustancia nos protege del exterior, especialmente de las bacterias que de forma habitual viven encima de nuestra piel. Cuando nuestra piel se daña o se debilita las bacterias pueden causar enfermedades, como el impétigo.
Aunque cualquier persona puede sufrir impétigo, es una enfermedad que afecta principalmente a niños pequeños. Aproximadamente el 1% de los niños europeos ha tenido impétigo en los últimos años. En Latinoamérica la cifra es algo superior, sobre todo entre los trópicos, donde hasta el 15% de las personas se ven afectadas en la infancia. Los adultos se afectan con mucha menos frecuencia, pero hay que tener en cuenta que también pueden hacerlo.
El impétigo debe ser tratado cuanto antes, no porque en sí mismo sea una enfermedad grave, sino porque es muy contagioso para las personas que están en contacto con el niño, y también porque en algunos pequeños desencadena una reacción del sistema inmunitario que daña a los riñones: la glomerulonefritis postinfecciosa.
Creado: 11 de enero de 2013